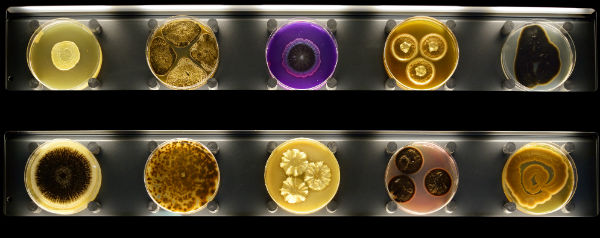

Het aan Artis grenzende ‘Micropia’ is een museum vol fascinerende micro-organismen. KIJK ging erheen.
Beschimmeld brood, rotte nectarines; in het dit najaar geopende Micropia liggen ze niet bij het GFT, maar netjes achter glas. Het alledaagse tot kunst verheven – Micropia is uniek en doodgewoon tegelijk. Uniek omdat het naar eigen zeggen het eerste museum over micro-organismen, zoals schimmels en bacteriën, ter wereld is. En doodgewoon omdat die organismen zo alomtegenwoordig zijn in ons dagelijks leven. Per persoon dragen we er al zo’n 100 biljoen (100.000 miljard) met ons mee. Dat is ruim anderhalve kilo!
De laatste tijd winnen microben aan populariteit. Eerst dankzij het boek Allemaal beestjes van wetenschapsjournalist en KIJK-medewerker Jop de Vrieze, nu dankzij Micropia. Het aan Artis grenzende museum is een mini-dierentuin vol fascinerende organismen, die onder andere door middel van 3D-kijkers en boeiende filmpjes zichtbaar worden gemaakt.
Er is ook de kiss-o-meter, waar je ongegeneerd kunt zoenen. Vervolgens wordt geanalyseerd hoeveel microben je daarbij hebt uitgewisseld.
**** | Micropia, Amsterdam | entree volwassene €14,-
Tekst: Gemma Venhuizen
Beeld: Maarten van der Wal